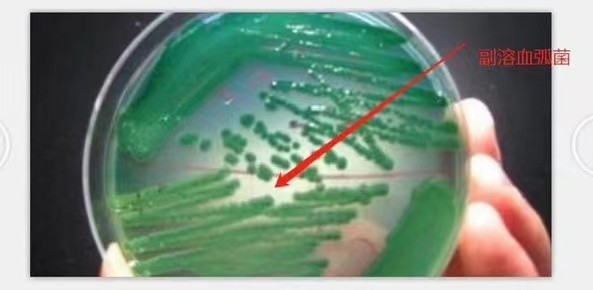

蛭弧菌是寄生于其他细菌并能导致其裂解的一类细菌。它虽然比一般的细菌小,中询生物微生物研发经过细菌滤器,有相似噬菌体的作用,来自但它不是病毒,确确实实是一类能“吃掉”细菌的细菌。

寄生型蛭弧菌成长,要求pH6.0~8.5;温度23~37℃,低于12℃、高于42℃时均不成长;能安稳分化蛋白质,一般不利用碳水化合物,而以肽、氨基酸作碳源和动力;能液化明胶;严厉好氧;在人工培养基上则产生黄色色素,细胞色素a、b、c,还能产生各种酶类。
蛭弧菌侵入宿主细菌的方式非常独特。开端时,它以很高的速度(每秒高达100个细胞长度劳低领连去局)猛烈磕碰宿主细胞,无鞭毛端直接附着于宿主细胞壁上。

然后,菌体以100转/秒以上的转速产生一种机械“钻孔”效应,加上蛭弧菌侵略时的缩短而进入宿主细胞的周质空间。从“钻孔”到进入只需几秒钟便可完结。在吸附至侵入开端前的5~10分钟,宿主细胞出现弯曲现象,这或许由于蛭弧菌产生的胞壁酸酶等使之转化为球质体的缘故。


由于TCBS弧菌检测培养基的特异性不强,容易造成误判,建议做进一步弧菌分离鉴定,亦可通过观察水体及养殖动物的吃料、活动等表观行为做参考。
中询生物温家团范批响名衡行振馨提示 本产品虽然安全性高,但也请放在儿童不宜接触的地方。